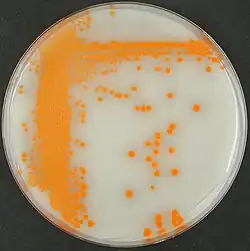

Actinoplanes teichomyceticus
| Actinoplanes teichomyceticus | |
|---|---|
| |
| Scientific classification | |
| Domain: | Bacteria |
| Kingdom: | Bacillati |
| Phylum: | Actinomycetota |
| Class: | Actinomycetes |
| Order: | Micromonosporales |
| Family: | Micromonosporaceae |
| Genus: | Actinoplanes |
| Species: | A. teichomyceticus
|
| Binomial name | |
| Actinoplanes teichomyceticus Wink et al. 2006
| |
| Type strain[1] | |
| AB8327 FH 2149 DSM 43866 ATCC 31121 BCRC 12106 FERM P-3462 IMSNU 20043 IMET 9254 JCM 3252 KCC A-0252 KCTC 9543 NBRC 13999 NCIMB 12640 NRRL B-16726 SANK 60479 | |
Actinoplanes teichomyceticus is an aerobic, spore-forming, mesophilic bacterium from the genus of Actinoplanes that was isolated from soil and produces antibiotic compounds.[2][3][4] In 1978, the strain ATCC 31121 of A. teichomyceticus was isolated from a soil sample from Nimodi Village, Indore, India, and was found to produce the antibiotic teicoplanin.[4][5]
References
- ^ Wink JM, Kroppenstedt RM, Schumann P, Seibert G, Stackebrandt E (September 2006). "Actinoplanes liguriensis sp. nov. and Actinoplanes teichomyceticus sp. nov". International Journal of Systematic and Evolutionary Microbiology. 56 (Pt 9): 2125–2130. doi:10.1099/ijs.0.64240-0. PMID 16957109.
- ^ "Species: Actinoplanes teichomyceticus". LPSN. October 29, 2023. Retrieved 24 December 2024.
- ^ "BacDive ID: 7818". BacDive. Retrieved December 24, 2024.
Text was copied from this source, which is available under a Creative Commons Attribution 4.0 International License Archived 16 October 2017 at the Wayback Machine.
- ^ a b Vimberg V (November 2021). "Teicoplanin-A New Use for an Old Drug in the COVID-19 Era?". Pharmaceuticals (Basel, Switzerland). 14 (12): 1227. doi:10.3390/ph14121227. PMC 8708781. PMID 34959628.
- ^ Parenti F, Beretta G, Berti M, Arioli V (April 1978). "Teichomycins, new antibiotics from Actinoplanes teichomyceticus Nov. Sp. I. Description of the producer strain, fermentation studies and biological properties". The Journal of Antibiotics. 31 (4): 276–83. doi:10.7164/antibiotics.31.276. PMID 659325.